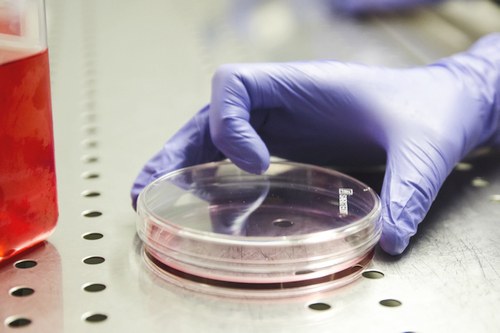

La personalizzazione delle sigarette elettroniche determina effetti tossicologici individuali
Modificando alcuni parametri del dispositivo si registrano livelli diversi di aldeidi tossiche nei vapori generati, con alterazioni significative a livello polmonare e con effetti anche sui marcatori di stress ossidativo, rivela un nuovo studio realizzato da un gruppo di ricercatori dell’Università di Bologna